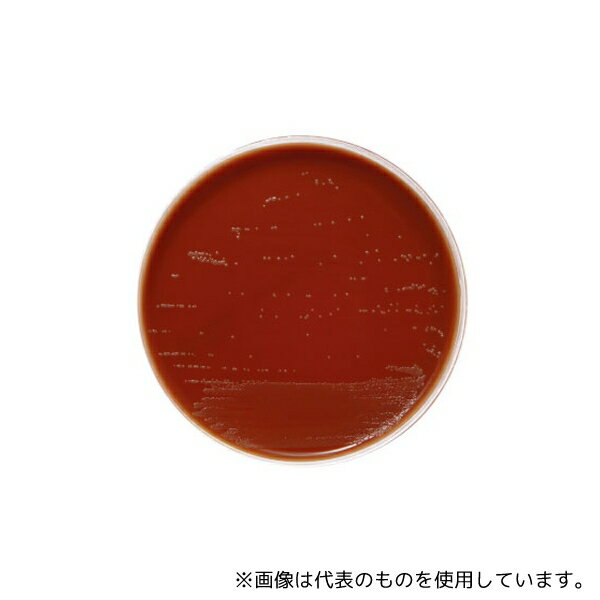
ベクトン・ディッキンソン 251138 BD BBL(TM) BYチョコレート寒天培地 20枚
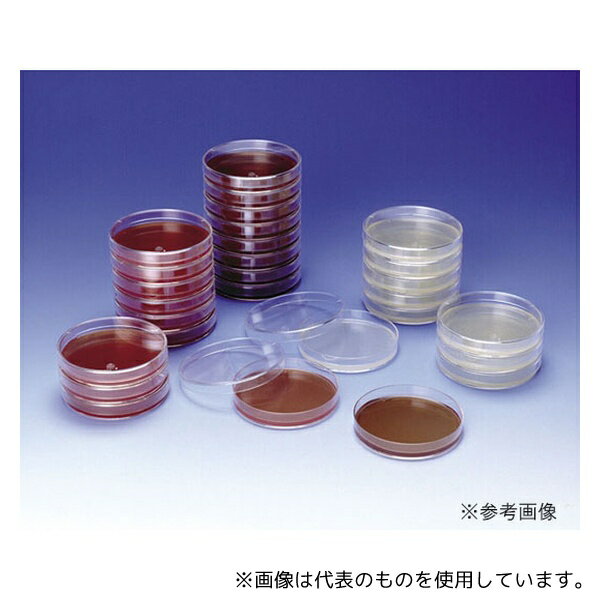
栄研化学 E-MS50 ポアメディア?チョコレート寒天培地II 10枚入
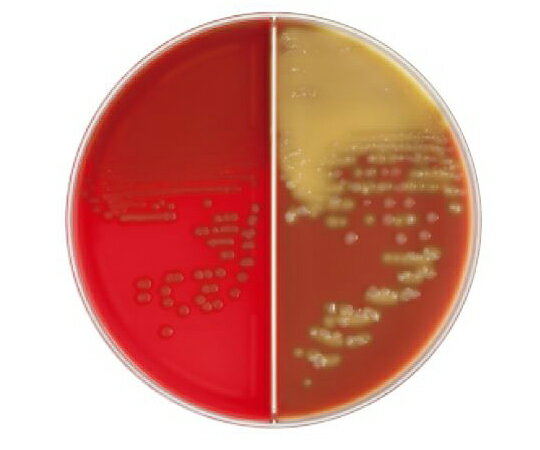
ベクトン・ディッキンソン BD BBL(TM) TSA5%ヒツジ血液寒天培地/チョコレート寒天培地 LDIP 100枚 1個(1本×100枚入) 251416
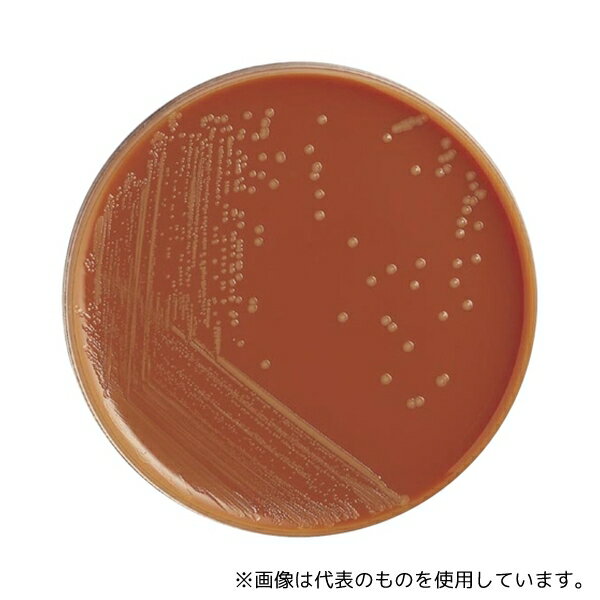
島津ダイアグノスティクス 51053 アキュレートチョコレート寒天培地—EXII10枚

栄研化学 E-MS50 ポアメディア?チョコレート寒天培地II 10枚入
ベクトン・ディッキンソン 251138 BD BBL(TM) BYチョコレート寒天培地 20枚

ベクトン・ディッキンソン BD BBL(TM) TSA5%ヒツジ血液寒天培地/チョコレート寒天培地 LDIP 100枚 1個(1本×100枚入) 251416

Incident ID: 063fb1d1-bohn-437e-a219-f81546d1d2a2 IP Address : 219.104.25.38

f:id:cacaotree:20201224181008j:image
栄研化学 E-MS50 ポアメディア?チョコレート寒天培地II 10枚入

馬伝染性ウマ子宮炎ウマ性病Taylorellaequigenitalisチョコレート寒天培地、ウマ, 寒天, 動物, 動物たち png

ベクトン・ディッキンソン BD BBL(TM) バシトラシン添加チョコレート寒天培地 20枚 1個(1本×20枚入) 256271

f:id:tominn:20180209150439j:plain:w500

ベクトン・ディッキンソン BD BBL(TM) TSA5%ヒツジ血液寒天培地/バシトラシン添加チョコレート寒天培地 20枚 1個(1本×20枚入) 251789

Incident ID: d0ee66f5-bohn-4e4d-ae24-836666d57a0b IP Address : 219.104.25.38

栄研化学 ぺたんチェック®DD DD寒天培地 PD0002(100枚)

ベクトン・ディッキンソン 251138 BD BBL(TM) BYチョコレート寒天培地 20枚

じんりんぎ 微生物研究班 日別アーカイブ: 2013/04/06 日々の検査から No.10

Trick recipes : Rich Ganache Soft Chocolate Bar なんちゃってチョコレート やわらかいチョコレート寒天 - YouTube
ベクトン・ディッキンソン BD BBL(TM) TSA5%ヒツジ血液寒天培地/チョコレート寒天培地 100枚 1個(1本×100枚入) 251303

Incident ID: 420ce046-bohn-4d41-9a4f-bcebcd0bbc5d IP Address : 219.104.25.38

臨床診断薬分野医療関係者向けサイト アキュレート™ チョコレート寒天培地EXⅡAccuRate™ Chocolate Agar EX Ⅱ
島津ダイアグノスティクス 51053 アキュレートチョコレート寒天培地—EXII10枚

島津ダイアグノスティクス 51053 アキュレートチョコレート寒天培地—EXII10枚